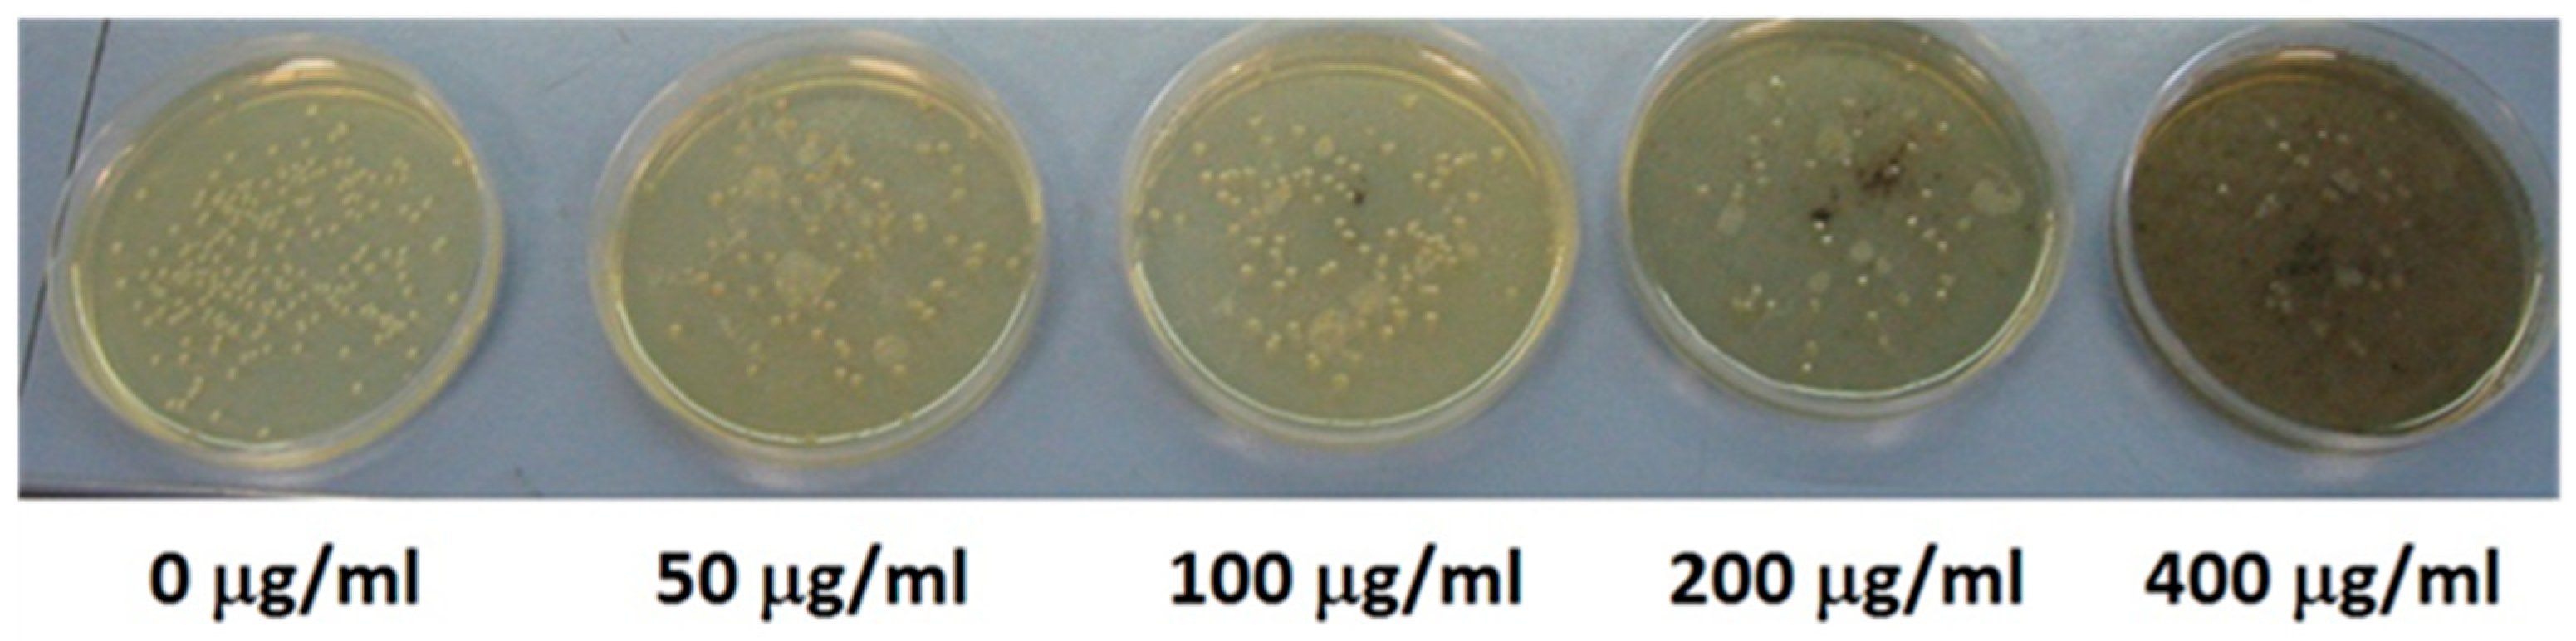

The Addition of Co into CuO–ZnO Oxides Triggers High Antibacterial Activity and Low Cytotoxicity
Abstract
1. Introduction
2. Materials and Methods
2.1. Reagents and Equipment
2.2. Synthetic Procedure
2.3. Bacterial Growth Inhibition Assay
2.4. Cytotoxicity Assays
3. Results
3.1. Precursors
3.1.1. XRD Patterns
3.1.2. Infrared Spectra
3.2. Mixed Oxides
3.2.1. XRD Patterns
3.2.2. SEM Images and EDX
3.3. E. coli Viability
3.4. Cytotoxicity Assays
4. Conclusions
Author Contributions
Funding
Data Availability Statement
Conflicts of Interest
References
- Antimicrobial Resistance. Available online: https://www.who.int/news-room/fact-sheets/detail/antimicrobial-resistance (accessed on 27 June 2023).
- Larsson, D.G.J.; Flach, C.-F.; Laxminarayan, R. Sewage surveillance of antibiotic resistance holds both opportunities and challenges. Nat. Rev. Microbiol. 2023, 21, 213–214. [Google Scholar] [CrossRef] [PubMed]
- Huan, Y.; Kong, Q.; Mou, H.; Yi, H. Antimicrobial Peptides: Classification, Design, Application and Research Progress in Multiple Fields. Front. Microbiol. 2020, 11, 582779. [Google Scholar] [CrossRef] [PubMed]
- León-Buitimea, A.; Garza-Cárdenas, C.R.; Garza-Cervantes, J.A.; Lerma-Escalera, J.A.; Morones-Ramírez, J.R. The Demand for New Antibiotics: Antimicrobial Peptides, Nanoparticles, and Combinatorial Therapies as Future Strategies in Antibacterial Agent Design. Front. Microbiol. 2020, 11, 1669. [Google Scholar] [CrossRef] [PubMed]
- Carvalho, T. A new class of antibiotics delivers promising trial results against tuberculosis. Nat. Med. 2023, 29, 4–5. [Google Scholar] [CrossRef]
- Fischbach, M.A. Combination therapies for combating antimicrobial resistance. Curr. Opin. Microbiol. 2011, 14, 519–523. [Google Scholar] [CrossRef]
- Sharmin, S.; Rahaman, M.; Sarkar, C.; Atolani, O.; Islam, M.T.; Adeyemi, O.S. Nanoparticles as antimicrobial and antiviral agents: A literature-based perspective study. Helyon 2021, 7, e06456. [Google Scholar] [CrossRef]
- Hemeg, H.A. Nanomaterials for alternative antibacterial therapy. Int. J. Nanomed. 2017, 12, 8211–8225. [Google Scholar] [CrossRef]
- Natan, M.; Banin, E. From nano to micro: Using nanotechnology to combat microorganisms and their multidrug resistance. FEMS Microbiol. Rev. 2017, 41, 302–322. [Google Scholar] [CrossRef]
- Bhattacharjee, S.; Joshi, R.; Yasir, M.; Adhikari, A.; Chughtai, A.A.; Heslop, D.; Bull, R.; Willcox, M.; Macintyre, C.R. Graphene- and Nanoparticle-Embedded Antimicrobial and Biocompatible Cotton/Silk Fabrics for Protective Clothing. ACS Appl. Bio Mater. 2021, 4, 6175–6185. [Google Scholar] [CrossRef]
- Madhusha, C.; Jayasundara, T.; Munaweera, I.; Perera, C.; Wijesinghe, G.; Weerasekera, M.; Sandaruwan, C.; Meiyazhagan, A.; Robles Hernandez, F.C.; Ajayan, P.M.; et al. Synthesis and structural characterization of copper nanoparticles doped activated carbon derived from coconut coir for drinking water purification. Mater. Today Chem. 2023, 27, 101312. [Google Scholar] [CrossRef]
- Ghamarpoor, R.; Jamshidi, M.; Fallah, A.; Eftekharipour, F. Preparation of dual-use GPTES@ZnO photocatalyst from waste warm filter cake and evaluation of its synergic photocatalytic degradation for air-water purification. J. Environ. Manag. 2023, 342, 118352. [Google Scholar] [CrossRef] [PubMed]
- Gronwald, B.; Kozłowska, L.; Kijak, K.; Lietz-Kijak, D.; Skomro, P.; Gronwald, K.; Gronwald, H. Nanoparticles in Dentistry—Current Literature Review. Coatings 2023, 13, 102. [Google Scholar] [CrossRef]
- Kędziora, A.; Wieczorek, R.; Speruda, M.; Matolínová, I.; Goszczyński, T.M.; Litwin, I.; Matolín, V.; Bugla-Płoskońska, G. Comparison of Antibacterial Mode of Action of Silver Ions and Silver Nanoformulations with Different Physico-Chemical Properties: Experimental and Computational Studies. Front. Microbiol. 2021, 12, 659614. [Google Scholar] [CrossRef] [PubMed]
- Tong, G.; Du, F.; Wu, W.; Wu, R.; Liu, F.; Liang, Y. Enhanced reactive oxygen species (ROS) yields and antibacterial activity of spongy ZnO/ZnFe2O4 hybrid micro-hexahedra selectively synthesized through a versatile glucoseengineered co-precipitation/annealing process. J. Mater. Chem. B 2013, 1, 2647–2657. [Google Scholar] [CrossRef]
- Singh, R.; Smitha, M.S.; Singh, S.P. The role of nanotechnology in combating multi-drug resistant bacteria. J. Nanosci. Nanotechnol. 2014, 14, 4745–4756. [Google Scholar] [CrossRef]
- Rai, M.; Ingle, A.P.; Pandit, R.; Paralikar, P.; Gupta, I.; Chaud, M.V.; Alves Dos Santos, C. Broadening the spectrum of small-molecule antibacterials by metallic nanoparticles to overcome microbial resistance. Int. J. Pharm. 2017, 532, 139–148. [Google Scholar] [CrossRef]
- Singh, R.; Nawale, L.; Arkile, M.; Wadhwani, S.; Shedbalkar, U.; Chopade, S.; Sarkar, D.; Chopade, B.A. Phytogenic silver, gold, and bimetallic nanoparticles as novel antitubercular agents. Int. J. Nanomed. 2016, 11, 1889–1897. [Google Scholar] [CrossRef][Green Version]
- Aderibigbe, B.A. Metal-based nanoparticles for the treatment of infectious diseases. Molecules 2017, 22, 1370. [Google Scholar] [CrossRef]
- Dash, K.K.; Deka, P.; Bangar, S.P.; Chaudhary, V.; Trif, M.; Rusu, A. Applications of inorganic nanoparticles in food packaging: A comprehensive review. Polymers 2022, 14, 521. [Google Scholar] [CrossRef]
- Slavin, Y.N.; Asnis, J.; Hafeli, U.O.; Bach, H. Metal nanoparticles: Understanding the mechanisms behind antibacterial activity. J. Nanobiotechnol. 2017, 15, 65. [Google Scholar] [CrossRef]
- Zaidi, S.; Misba, L.; Khan, A.U. Nano-therapeutics: A revolution in infection control in post antibiotic era. Nanomed. Nanotechnol. Biol. Med. 2017, 13, 2281–2301. [Google Scholar] [CrossRef] [PubMed]
- Bassegoda, A.; Ivanova, K.; Ramon, E.; Tzanov, T. Strategies to prevent the occurrence of resistance against antibiotics by using advanced materials. Appl. Microbiol. Biotechnol. 2018, 102, 2075–2089. [Google Scholar] [CrossRef] [PubMed]
- AlMatar, M.; Makky, E.A.; Var, I.; Koksal, F. The role of nanoparticles in the inhibition of multidrug-resistant bacteria and biofilms. Curr. Drug Deliv. 2017, 15, 470–484. [Google Scholar] [CrossRef] [PubMed]
- Zhang, W.; Zhang, Z.-P.; Zhang, X.-E.; Li, F. Reaction inside a viral protein nanocage: Mineralization on a nanoparticle seed after encapsulation via self-assembly. Nano Res. 2017, 10, 3285–3294. [Google Scholar] [CrossRef]
- Cai, L.; Zhu, X.; Ruan, H.; Yang, J.; Wei, W.; Wu, Y.; Zhou, L.; Jiang, H.; Ji, M.; Chen, J. Curcumin-stabilized silver nanoparticles encapsulated in biocompatible electrospun nanofibrous scaffold for sustained eradication of drug-resistant bacteria. J. Hazard. Mater. 2023, 452, 131290. [Google Scholar] [CrossRef]
- Aoki, S.; Yamakawa, K.; Kubo, K.; Takeshita, J.; Takeuchi, M.; Nobuoka, Y.; Wada, R.; Kikuchi, M.; Sawai, J. Antibacterial Properties of Silicone Membranes after a Simple Two-Step Immersion Process in Iodine and Silver Nitrate Solutions. Biocontrol Sci. 2018, 23, 97–105. [Google Scholar] [CrossRef]
- Carbone, M.; Piancastelli, M.N.; Casaletto, M.P.; Zanoni, R.; Besnard-Ramage, M.J.; Comtet, G.; Dujardin, G.; Hellner, L. Phenol adsorption on Si(111)7×7 studied by synchrotron radiation photoemission and photodesorption. Surf. Sci. 1999, 419, 114–119. [Google Scholar] [CrossRef]
- Carbone, M.; Zanoni, R.; Piancastelli, M.N.; Comtet, G.; Dujardin, G.; Hellner, L. Synchrotron radiation photoemission and photostimulated desorption of deuterated methanol on Si(111)7×7 and Si(100)2×1. Surf. Sci. 1996, 352–354, 391–395. [Google Scholar] [CrossRef]
- Baptista, P.V.; McCusker, M.P.; Carvalho, A.; Ferreira, D.A.; Mohan, N.M.; Martins, M.; Fernandes, A.R. Nano-Strategies to Fight Multidrug Resistant Bacteria—A Battle of the Titans. Front. Microbiol. 2018, 9, 1441. [Google Scholar] [CrossRef]
- Reshma, V.G.; Syama, S.; Sruthi, S.; Reshma, S.C.; Remya, N.S.; Mohanan, P.V. Engineered nanoparticles with antimicrobial property. Curr. Drug Metab. 2017, 18, 1040–1054. [Google Scholar] [CrossRef]
- Raghunath, A.; Perumal, E. Metal oxide nanoparticles as antimicrobial agents: A promise for the future. Int. J. Antimicrob. Agents 2017, 49, 137–152. [Google Scholar] [CrossRef] [PubMed]
- Kadiyala, U.; Kotov, N.A.; VanEpps, J.S. Antibacterial metal oxide nanoparticles: Challenges in interpreting the literature. Curr. Pharm. Des. 2018, 24, 896–903. [Google Scholar] [CrossRef] [PubMed]
- Ghirardello, M.; Ramos-Soriano, J.; Galan, M.C. Carbon Dots as an Emergent Class of Antimicrobial Agents. Nanomaterials 2021, 11, 1877. [Google Scholar] [CrossRef] [PubMed]
- Hao, X.; Huang, L.; Zhao, C.; Chen, S.; Lin, W.; Lin, Y.; Zhang, L.; Sun, A.; Miao, C.; Lin, X.; et al. Antibacterial activity of positively charged carbon quantum dots without detectable resistance for wound healing with mixed bacteria infection. Mater. Sci. Eng. C 2021, 123, 11971. [Google Scholar] [CrossRef]
- Chai, S.; Zhou, L.; Pei, S.; Zhu, Z.; Chen, B. P-Doped Carbon Quantum Dots with Antibacterial Activity. Micromachines 2021, 12, 1116. [Google Scholar] [CrossRef]
- Limosani, F.; Bauer, E.M.; Cecchetti, D.; Biagioni, S.; Orlando, V.; Pizzoferrato, R.; Prosposito, P.; Carbone, M. Top-Down N-Doped Carbon Quantum Dots for Multiple Purposes: Heavy Metal Detection and Intracellular Fluorescence. Nanomaterials 2021, 11, 2249. [Google Scholar] [CrossRef]
- Babazadeh, S.; Bisauriya, R.; Carbone, M.; Roselli, L.; Cecchetti, D.; Bauer, E.M.; Sennato, S.; Prosposito, P.; Pizzoferrato, R. Colorimetric Detection of Chromium(VI) Ions in Water Using Unfolded-Fullerene Carbon Nanoparticles. Sensors 2021, 21, 6353. [Google Scholar] [CrossRef]
- Qie, X.; Zan, M.; Gui, P.; Chen, H.; Wang, J.; Lin, K.; Mei, Q.; Ge, M.; Zhang, Z.; Tang, Y.; et al. Design, Synthesis, and Application of Carbon Dots With Synergistic Antibacterial Activity. Front. Bioeng. Biotechnol. 2022, 10, 894100. [Google Scholar] [CrossRef]
- Valentini, F.; Ciambella, E.; Boaretto, A.; Rizzitelli, G.; Carbone, M.; Conte, V.; Cataldo, F.; Russo, V.; Casari, C.S.; Chillura-Martino, D.F.; et al. Sensor Properties of Pristine and Functionalized Carbon Nanohorns. Electroanalysis 2016, 28, 2489–2499. [Google Scholar] [CrossRef]
- Carbone, M.; Sabbatella, G.; Antonaroli, S.; Remita, H.; Orlando, V.; Biagioni, S.; Nucara, A. Exogenous Control over Intracellular Acidification: Enhancement via Proton Caged Compounds Coupled to Gold Nanoparticles. Biochim. Biophys. Acta Gen. Subj. 2015, 1850, 2304–2307. [Google Scholar] [CrossRef]
- Arias, L.S.; Pessan, J.P.; Vieira, A.P.M.; de Lima, T.M.T.; Delbem, A.C.B.; Monteiro, D.R. Iron Oxide Nanoparticles for Biomedical Applications: A Perspective on Synthesis, Drugs, Antimicrobial Activity, and Toxicity. Antibiotics 2018, 7, 46. [Google Scholar] [CrossRef] [PubMed]
- Nishino, F.; Jeem, M.; Zhang, L.; Okamoto, K.; Okabe, S.; Watanabe, S. Formation of CuO nano-flowered surfaces via submerged photosynthesis of crystallites and their antimicrobial activity. Sci. Rep. 2017, 7, 1063. [Google Scholar] [CrossRef] [PubMed]
- LewisOscar, F.; MubarakAli, D.; Nithya, C.; Priyanka, R.; Gopinath, V.; Alharbi, N.S.; Thajuddin, N. One pot synthesis and anti-biofilm potential of copper nanoparticles (CuNPs) against clinical strains of Pseudomonas aeruginosa. Biofouling 2015, 31, 379–391. [Google Scholar] [CrossRef] [PubMed]
- Kruk, T.; Szczepanowicz, K.; Stefanska, J.; Socha, R.P.; Warszynski, P. Synthesis and antimicrobial activity of monodisperse copper nanoparticles. Colloids Surf. B Biointerfaces 2015, 128, 17–22. [Google Scholar] [CrossRef] [PubMed]
- Bezza, F.A.; Tichapondwa, S.M.; Chirwa, E.M.N. Fabrication of monodispersed copper oxide nanoparticles with potential application as antimicrobial agents. Sci. Rep. 2020, 10, 16680. [Google Scholar] [CrossRef] [PubMed]
- Su, Y.; Zheng, X.; Chen, Y.; Li, M.; Liu, K. Alteration of intracellular protein expressions as a key mechanism of the deterioration of bacterial denitrification caused by copper oxide nanoparticles. Sci. Rep. 2015, 5, 15824. [Google Scholar] [CrossRef]
- Hsueh, Y.H.; Ke, W.J.; Hsieh, C.T.; Lin, K.S.; Tzou, D.Y.; Chiang, C.L. ZnO nanoparticles affect bacillus subtilis cell growth and biofilm formation. PLoS ONE 2015, 10, e0128457. [Google Scholar] [CrossRef]
- Sarwar, S.; Chakraborti, S.; Bera, S.; Sheikh, I.A.; Hoque, K.M.; Chakrabarti, P. The antimicrobial activity of ZnO nanoparticles against Vibrio cholerae: Variation in response depends on biotype. Nanomed. Nanotechnol. Biol. Med. 2016, 12, 1499–1509. [Google Scholar] [CrossRef]
- Sirelkhatim, A.; Mahmud, S.; Seeni, A.; Kaus, N.H.M.; Ann, L.C.; Bakhori, S.K.M.; Hasan, H.; Mohamad, D. Review on Zinc Oxide Nanoparticles: Antibacterial Activity and Toxicity Mechanism. Nano-Micro Lett. 2015, 7, 219–242. [Google Scholar] [CrossRef]
- El-Masry, R.M.; Talat, D.; Hassoubah, S.A.; Zabermawi, N.M.; Eleiwa, N.Z.; Sherif, R.M.; Abourehab, M.A.S.; Abdel-Sattar, R.M.; Gamal, M.; Ibrahim, M.S.; et al. Evaluation of the Antimicrobial Activity of ZnO Nanoparticles against Enterotoxigenic Staphylococcus aureus. Life 2022, 12, 1662. [Google Scholar] [CrossRef]
- Babayevska, N.; Przysiecka, Ł.; Iatsunskyi, I.; Nowaczyk, G.; Jarek, M.; Janiszewska, E.; Jurga, S. ZnO size and shape effect on antibacterial activity and cytotoxicity profile. Sci. Rep. 2022, 12, 8148. [Google Scholar] [CrossRef] [PubMed]
- Anele, A.; Obare, S.; Wei, J. Recent Trends and Advances of Co3O4 Nanoparticles in Environmental Remediation of Bacteria in Wastewater. Nanomaterials 2022, 12, 1129. [Google Scholar] [CrossRef] [PubMed]
- Zhu, X.; Li, H.; Zhou, L.; Jiang, H.; Ji, M.; Chen, J. Evaluation of the gut microbiome alterations in healthy rats after dietary exposure to different synthetic ZnO nanoparticles. Life Sci. 2023, 312, 121250. [Google Scholar] [CrossRef] [PubMed]
- Aguado, S.; Quirós, J.; Canivet, J.; Farrusseng, D.; Boltes, K.; Rosal, R. Antimicrobial activity of cobalt imidazolate metal–organic frameworks. Chemosphere 2014, 113, 188–192. [Google Scholar] [CrossRef] [PubMed]
- Alam, M.W.; Al Qahtani, H.S.; Souayeh, B.; Ahmed, W.; Albalawi, H.; Farhan, M.; Abuzir, A.; Naeem, S. Novel, Copper-Zinc-Manganese Ternary Metal Oxide Nanocomposite as Heterogeneous Catalyst for Glucose Sensor and Antibacterial Activity. Antioxidants 2022, 11, 1064. [Google Scholar] [CrossRef]
- Suresh, J.; Ragunath, L.; Hong, S.I. Biosynthesis of mixed nanocrystalline Zn–Mg–Cu oxide nanocomposites and their antimicrobial behavior. Adv. Nat. Sci. Nanosci. Nanotechnol. 2019, 10, 045014. [Google Scholar] [CrossRef]
- Cuadra, J.G.; Molina-Prados, S.; Mínguez-Vega, G.; Estrada, A.C.; Trindade, T.; Oliveira, C.; Seabra, M.P.; Labrincha, J.; Porcar, S.; Cadena, R.; et al. Multifunctional silver-coated transparent TiO2 thin films for photocatalytic and antimicrobial applications. Appl. Surf. Sci. 2023, 617, 156519. [Google Scholar] [CrossRef]
- Sinha, R.; Karan, R.; Sinha, A.; Khare, S.K. Interaction and nanotoxic effect of ZnO and Ag nanoparticles on mesophilic and halophilic bacterial cells. Bioresour. Technol. 2011, 102, 1516–1520. [Google Scholar] [CrossRef]
- Carbone, M.; Aneggi, E.; Figueredo, F.; Susmel, S. NiO-Nanoflowers Decorating a Plastic Electrode for the Non-Enzymatic Amperometric Detection of H2O2 in Milk: Old Issue, New Challenge. Food Control 2022, 132, 108549. [Google Scholar] [CrossRef]
- Carbone, M. CQDs@NiO: An Efficient Tool for CH4 Sensing. Appl. Sci. 2020, 10, 6251. [Google Scholar] [CrossRef]
- Carbone, M.; Missori, M.; Micheli, L.; Tagliatesta, P.; Bauer, E.M. NiO Pseudocapacitance and Optical Properties: Does the Shape Win? Materials 2020, 13, 1417. [Google Scholar] [CrossRef]
- Carbone, M.; Tagliatesta, P. NiO Grained-Flowers and Nanoparticles for Ethanol Sensing. Materials 2020, 13, 1880. [Google Scholar] [CrossRef]
- Patel, M.; Mishra, S.; Verma, R.; Shikha, D. Synthesis of ZnO and CuO nanoparticles via Sol gel method and its characterization by using various technique. Discov. Mater. 2022, 2, 1. [Google Scholar] [CrossRef]
- Keabadile, P.; Aremu, A.O.; Elugoke, S.E.; Fayemi, O.E. Green and Traditional Synthesis of Copper Oxide Nanoparticles—Comparative Study. Nanomaterials 2020, 10, 2502. [Google Scholar] [CrossRef] [PubMed]
- Zhang, Q.; Zhang, K.; Xu, D.; Yang, G.; Huang, H.; Nie, F.; Liu, C.; Yang, S. CuO nanostructures: Synthesis, characterization, growth mechanisms, fundamental properties, and applications. Progress Mater. Sci. 2014, 60, 208–337. [Google Scholar] [CrossRef]
- Carbone, M. Zn Defective ZnCo2O4 Nanorods as High Capacity Anode for Lithium Ion Batteries. J. Electroanal. Chem. 2018, 815, 151–157. [Google Scholar] [CrossRef]
- Gontrani, L.; Donia, D.T.; Bauer, E.M.; Tagliatesta, P.; Carbone, M. Novel Synthesis of Zinc Oxide Nanoparticles from Type IV Deep Eutectic Solvents. Inorg. Chim. Acta 2023, 545, 121268. [Google Scholar] [CrossRef]
- JCPDS-ICDD 41-1390. International Centre for Diffraction Data, Newtown Square, PA, USA.
- JCPDS-ICDD 72-1100. International Centre for Diffraction Data, Newtown Square, PA, USA.
- JCPDS-ICDD 48-0083. International Centre for Diffraction Data, Newtown Square, PA, USA.
- Yang, J.; Cheng, H.; Frost, R.L. Synthesis and characterisation of cobalt hydroxy carbonate Co2CO3(OH)2 nanomaterials. Spectrochim. Acta Part A 2011, 78, 420–428. [Google Scholar] [CrossRef]
- Carbone, M. Cu Zn Co Nanosized Mixed Oxides Prepared from Hydroxycarbonate Precursors. J. Alloys Compd. 2016, 688, 202–209. [Google Scholar] [CrossRef]
- Carbone, M.; Briancesco, R.; Bonadonna, L. Antimicrobial Power of Cu/Zn Mixed Oxide Nanoparticles to Escherichia coli. Environ. Nanotechnol. Monit. Manag. 2017, 7, 97–102. [Google Scholar] [CrossRef]
- Schmidt, M.; Lutz, H.D. Hydrogen bonding in basic copper salts: A spectroscopic study of malachite, Cu2(OH)2CO3, and brochanite, Cu4(OH)6SO4. Phys. Chem. Miner. 1993, 20, 27. [Google Scholar] [CrossRef]
- Braithwaite, R.S.W.; Ryback, G. Rosasite, aurichalcite, and associated minerals for Heights of Abraham, Matlock Bath, Derbyshire, with a note on infra-red spectra. Mineral. Mag. 1963, 33, 441–449. [Google Scholar] [CrossRef]
- Behrens, M.; Grigsdies, F.; Trunschke, A.; Schlögl, R. Minerals as Model Compounds for Cu/ZnO Catalyst Precursors: Structural and Thermal Properties and IR Spectra of Mineral and Synthetic (Zincian) Malachite, Rosasite and Auricalcite and a Catalyst Precursor Mixture. Eur. J. Inorg. Chem. 2009, 2009, 1347–1357. [Google Scholar] [CrossRef]
- Kondrat, S.A.; Smith, P.J.; Wells, P.P.; Chater, P.A.; Carter, J.H.; Morgan, D.J.; Fiordaliso, E.M.; Wagner, J.B.; Davies, T.E.; Lu, L.; et al. Stable amorphous georgeite as a precursor to a high-activity catalyst. Nature 2016, 531, 83–87. [Google Scholar] [CrossRef] [PubMed]
- Stoilova, D.; Koleva, V.; Vassileva, V. Infrared study of some synthetic phases of malachite (Cu2(OH)2CO3)-hydrozincite (Zn5(OH)6(CO3)2) series. Spectrochim. Acta A 2002, 58, 2051. [Google Scholar] [CrossRef]
- Pollard, A.M.; Spencer, M.S.; Thomas, R.G.; Williams, P.A.; Holt, J.; Jennings, J.R. Georgeite and azurite as precursors in the preparation of co-precipitated copper/zinc oxide catalysts. Appl. Catal. A Gen. 1992, 85, 1–11. [Google Scholar] [CrossRef]
- Bems, B.; Schur, M.; Dassenoy, A.; Junkes, H.; Herein, D.; Schlögl, R. Relations between Synthesis and Microstructural Properties of Copper/Zinc Hydroxycarbonates. Chem. Eur. J. 2003, 9, 2039–2052. [Google Scholar] [CrossRef]
- Zhou, T.; Gao, W.; Wang, Q.; Umar, A. Effect of Fluoride on the Morphology and Electrochemical Property of Co3O4 nanostructures for Hydrazine Detection. Materials 2018, 11, 207. [Google Scholar] [CrossRef]
- Nassar, M.Y.; Ahmed, I.S. Hydrothermal synthesis of cobalt carbonates using different counter ions: An efficient precursor to nano-sized cobalt oxide (Co3O4). Polyhedron 2011, 30, 2431–2437. [Google Scholar] [CrossRef]
- Musić, S.; Popović, S.; Maljković, M.; Dragčević, Ð. Influence of synthesis procedure on the formation and properties of zinc oxide. J. Alloys Compd. 2002, 347, 324–332. [Google Scholar] [CrossRef]
- Millar, G.J.; Holm, I.H.; Uwins, P.J.R.; Drennan, J. Characterization of precursors to methanol synthesis catalysts Cu/ZnO system. J. Chem. Soc. Faraday Trans. 1998, 94, 593–600. [Google Scholar] [CrossRef]
- Zwiener, L.; Grigsdies, F.; Brennecke, D.; Teschner, D.; Machoke, A.G.F.; Schlögl, R.; Frei, E. Evolution of zincian malachite synthesis by low temperature co-precipitation and its catalytic impact on the methanol synthesis. Appl. Catalysis B Environ. 2019, 249, 218–226. [Google Scholar] [CrossRef]
- JCPDS-ICDD 41-254. International Centre for Diffraction Data, Newtown Square, PA, USA.
- Gontrani, L.; Bauer, E.M.; Talone, A.; Missori, M.; Imperatori, P.; Tagliatesta, P.; Carbone, M. CuO Nanoparticles and Microaggregates: An Experimental and Computational Study of Structure and Electronic Properties. Materials 2023, 16, 4800. [Google Scholar] [CrossRef] [PubMed]
- JCPDS-ICDD 36-1451. International Centre for Diffraction Data, Newtown Square, PA, USA.
- JCPDS-ICDD 74-1657. International Centre for Diffraction Data, Newtown Square, PA, USA.
- Wilson, D.A.; Guring, K.; Langell, M.A. Effect of zinc substitution on the growth morphology of ZnO-CuO tenorite solid solutions. J. Cryst. Growth 2021, 562, 126062. [Google Scholar] [CrossRef]
- Donia, D.T.; Bauer, E.M.; Missori, M.; Roselli, L.; Cecchetti, D.; Tagliatesta, P.; Gontrani, L.; Carbone, M. Room Temperature Syntheses of ZnO and Their Structures. Symmetry 2021, 13, 733. [Google Scholar] [CrossRef]
- Ivask, A.; Titma, T.; Visnapuu, M.; Vija, H.; Käkinen, A.; Sihtmäe, M.; Pokhrel, S.; Mädler, L.; Heinlaan, M.; Kisand, V.; et al. Toxicity of 11 Metal Oxide Nanoparticles to Three Mammalian cell Types In vitro. Curr. Top. Med. Chem. 2015, 15, 1914–1929. [Google Scholar] [CrossRef]
- Cappellini, F.; Hedberg, Y.; McCarrick, S.; Hedberg, J.; Derr, R.; Gendriks, G.; Odnevall Wallinder, I.; Karlsson, H.L. Mechanistic insight into reactivity and (geno)toxicity of well-characterized nanoparticles of cobalt metal and oxides. Nanotoxicology 2018, 12, 602–620. [Google Scholar] [CrossRef]
- Quest GraphTM IC50 Calculator, AAT Bioquest, Inc. 4 September 2023. Available online: https://www.aatbio.com/tools/ic50-calculator (accessed on 7 September 2023).
- Reddy, A.R.N.; Lonkala, S. In vitro evaluation of copper oxide nanoparticle-induced cytotoxicity and oxidative stress using human embryonic kidney cells. Toxicol. Indust. Health 2019, 35, 159–164. [Google Scholar] [CrossRef]
- Soria, C.N.G.; Aga, D.S.; Atilla-Gokcumen, G.E. Lipidomics reveals insights on the biological effects of copper oxide nanoparticles in a human colon carcinoma cell line. Mol. Omics 2019, 15, 20–38. [Google Scholar] [CrossRef]
- Kumari, P.; Panda, P.K.; Jha, E.; Pramanik, N.; Nisha, D.; Kumari, K.; Soni, N.; Mallick, M.A.; Verma, S.K. Molecular insight to in vitro biocompatibility of phytofabricated copper oxide nanoparticles with human embryonic kidney cells. Nanomedicine 2018, 13, 2415–2433. [Google Scholar] [CrossRef]
- Choudhury, S.R.; Ordaz, J.; Lo, C.-L.; Damayanti, N.P.; Zhou, F.; Irudayaraj, J. Zinc oxide Nanoparticles-Induced Reactive Oxygen Species Promotes Multimodal Cyto- and Epigenetic Toxicity. Toxicol. Sci. 2017, 156, 261–274. [Google Scholar] [CrossRef] [PubMed]
- Ntombela, Z.G.; Pullabhotla, V.S.R.; Basson, A.K. Biosafety, Optimization, and application of Bioflocculant-Synthesized Zinc Oxide Nanoparticles. BioNanoScience 2022, 12, 1289–1304. [Google Scholar] [CrossRef]
- Dua, P.; Chaudhari, K.N.; Lee, C.H.; Chaudhari, N.K.; Hong, S.W.; Yu, J.-S.; Kim, S.; Lee, D. Evaluation of Toxicity and Gene Expression Changes Triggered by Oxide Nanoparticles. Bull. Korean Chem. Soc. 2011, 32, 2051–2057. [Google Scholar] [CrossRef][Green Version]
- Wahab, R.; Kaushik, N.K.; Kaushik, N.; Choi, E.H.; Umar, A.; Dwivedi, S.; Musarrat, J.; Al-Khedhairy, A.A. ZnO Nanoparticles Induces Cell Death in Malignant Human T98G Gliomas, KB and Non-Malignant HEK Cells. J. Biomed. Nanotechnol. 2013, 9, 1181–1189. [Google Scholar] [CrossRef]
- Reshma, V.G.; Mohanan, P.V. Cellular interactions of zinc oxide nanoparticles with human embryonic kidney (HEK 293) cells. Colloids Surf. B Biointerfaces 2017, 157, 182–190. [Google Scholar] [CrossRef]
- Cavallo, D.; Ciervo, A.; Fresegna, A.M.; Maiello, R.; Tassone, P.; Buresti, G.; Casciardi, S.; Iavicoli, S.; Ursini, C.L. Investigation on cobalt-oxide nanoparticles cyto-genotoxicity and inflammatory response in two types of respiratory cells. J. Appl. Toxicol. 2015, 35, 1102–1113. [Google Scholar] [CrossRef]
- Yuan, R.; Xu, H.; Liu, X.; Tian, Y.; Li, C.; Chen, Z.; Su, S.; Pereshtein, I.; Gedanken, A.; Lin, X. Zinc-doped Copper Oxide Nanocomposites Inhibit the Growth of Human Cancer Cells through Reactive Oxygen Species-Mediated NF-κB Activations. ACS Appl. Mater. Interfaces 2016, 8, 31806–31812. [Google Scholar] [CrossRef]
- Piret, J.P.; Jacques, D.; Audinot, J.N.; Mejia, J.; Boilan, E.; Noël, F.; Fransolet, M.; Demazy, C.; Lucas, S.; Saout, C.; et al. Copper (II) Oxide Nanoparticles Penetrate into HepG2 Cells, Exert Cytoxicity via Oxidative Stress and Induce Pro-inflammatory Response. Nanoscale 2012, 4, 7168–7184. [Google Scholar] [CrossRef]
- Xu, H.; Yuan, R.; Liu, Z.; Li, Z.; Qiao, G.; Li, C.; Gedanken, A.; Lin, X. Zn-doped CuO nanocompsites inhibit tumor growth by NF-κB pathway cross-linked autophagy and apoptosis. Nanomedicine 2018, 14, 131–149. [Google Scholar] [CrossRef]
- Karlsson, H.L.; Gustafsson, J.; Cronholm, P.; Möller, L. Size-dependent toxicity of metal oxide particles—A comparison between nano- and micrometer size. Toxicol. Lett. 2009, 188, 112–118. [Google Scholar] [CrossRef]
- Karlsson, H.L.; Cronholm, P.; Gustafsson, J.; Möller, L. Copper Oxide Nanoparticles Are Highly Toxic: A Comparison between Metal Oxide Nanoparticles and Carbon Nanotubes. Chem. Res. Toxicol. 2008, 21, 1726–1732. [Google Scholar] [CrossRef] [PubMed]
- Kung, M.-L.; Hsieh, S.-L.; Wu, C.-C.; Chu, T.-W.; Lin, Y.-C.; Yeh, B.-W.; Hsie, S. Enhanced rative oxygen species overexpression by CuO nanoparticles in poorly differentiated hepatocellular carcinoma cells. Nanoscale 2015, 7, 20–38. [Google Scholar] [CrossRef] [PubMed]
- Kim, B.; Kim, G.; Jeon, S.; Cho, W.-S.; Jeon, H.P.; Jung, J. Zinc oxide nanoparticles trigger autophagy-mediated cell death through activating lysosomal TRPML1 in normal kidney cells. Toxicol. Rep. 2023, 10, 529–536. [Google Scholar] [CrossRef] [PubMed]
- Peters, K.; Unger, R.E.; Gatti, A.M.; Sabbioni, E.; Tsarky, R.; Kirkpatrick, C.J. Metallic nanoparticles exhibit paradoxical effects on oxidative stress and pro-inflammatory responses in entothelial cells in vitro. Int. J. Immunopathol. Pharmacol. 2007, 20, 685–695. [Google Scholar] [CrossRef]
- Chattopadhyah, S.; Dash, S.K.; Tripath, S.; Das, B.; Mandal, D.; Pramanik, P.; Roy, S. Toxicity of cobalt oxide nanoparticles in normal cells, an in vitro and in vivo study. J. Appl. Toxicol. 2015, 226, 58–71. [Google Scholar] [CrossRef] [PubMed]
- Abudayyak, M.; Gurkaynak, T.A.; Özhan, G. In vitro evaluation of cobalt oxide nanoparticle-induced toxicity. Toxicol. Ind. Health 2017, 33, 646–654. [Google Scholar] [CrossRef] [PubMed]

| Precursor | Oxide | Cu | Zn | Co |
|---|---|---|---|---|
| Cu100p | Cu100 | 100 | -- | -- |
| Zn100p | Zn100 | -- | 100 | -- |
| Co100p | Co100 | -- | -- | 100 |
| Cu90Zn10p | Cu90Zn10 | 90 | 10 | -- |
| Cu80Zn20p | Cu80Zn20 | 80 | 20 | -- |
| Cu70Zn30p | Cu70Zn30 | 70 | 30 | -- |
| Cu60Zn40p | Cu60Zn40 | 60 | 40 | -- |
| Cu87Zn10Co3p | Cu87Zn10Co3 | 87 | 10 | 3 |
| Cu85Zn9Co6p | Cu85Zn9Co6 | 85 | 9 | 6 |
| Tenorite | Zincite | ||||||||
|---|---|---|---|---|---|---|---|---|---|
| % | a (Å) | b (Å) | c (Å) | V (Å3) | % | a(Å) | c (Å) | V (Å3) | |
| Sample | |||||||||
| Cu100 | 100 | 5.133 | 3.430 | 4.678 | 81.2 | -- | |||
| Cu90Zn10 | 100 | 5.155 | 3.395 | 4.738 | 81.8 | -- | |||
| Cu80Zn20 | 89.8 | 5.150 | 3.403 | 4.731 | 81.7 | 10.2 | 3.250 | 5.206 | 47.9 |
| Cu70Zn30 | 80.3 | 5.151 | 3.402 | 4.726 | 81.7 | 19.7 | 3.249 | 5.206 | 47.9 |
| Cu60Zn40 | 79.4 | 5.146 | 3.402 | 4.724 | 81.6 | 30.6 | 3.251 | 5.205 | 48.0 |
| Cu87Zn10Co3 | 100 | 5.153 | 3.399 | 4.735 | 81.8 | -- | |||
| Cu85Zn9Co6 | 100 | 5.150 | 3.425 | 4.737 | 81.8 | -- | |||
| Zn100 | -- | 100 | 3.249 | 5.205 | 47.9 | ||||
| Sample | Dim 1 | Dim2 | Aggr. Range | Shape |
|---|---|---|---|---|
| Cu100 | 20.3 ± 5.2 nm | -- | Nanoparticles | |
| Zn100 | 50.2 ± 5.1 nm | 250 ± 15 nm | Filament | |
| Co100 | 20.1 ± 5.3 nm | -- | Nanoparticles | |
| Cu90Zn10 | 20.3 ± 9.9 nm | Nanoparticles | ||
| Cu80Zn20 | 27.0 ± 5.6 nm | 205–250 nm | Hydrangea-like | |
| Cu70Zn30 | 29.9 ± 6.0 nm | 140–295 nm | Hydrangea-like | |
| Cu60Zn40 | 32.6 ± 6.2 nm | 140–230 nm | Hydrangea-like | |
| Cu87Zn10Co3 | 23.4 ± 5.8 nm | 110–280 nm | Hydrangea-like | |
| Cu85Zn9Co6 | 28.3 ± 5.4 nm | 140–280 nm | Hydrangea-like |
| Sample | Cu at% | Zn at% | Co at% | O at% |
|---|---|---|---|---|
| Cu100 | 49.9 | 0.0 | 0.0 | 49.9 |
| Zn100 | 0.0 | 49.7 | 0.0 | 50.1 |
| Co100 | 0.0 | 0.0 | 42.7 | 57.1 |
| Cu90Zn10 | 44.9 | 5.2 | 0.0 | 49.8 |
| Cu80Zn20 | 39.7 | 9.8 | 0.0 | 50.2 |
| Cu70Zn30 | 34.8 | 14.6 | 0.0 | 50.2 |
| Cu60Zn40 | 29.9 | 19.8 | 0.0 | 50.0 |
| Cu87Zn10Co3 | 43.5 | 5.0 | 1.6 | 49.8 |
| Cu85Zn9Co6 | 42.3 | 4.3 | 3.1 | 50.1 |
| NPs | Dimension (nm) | Shape | Cell Line | Conc. Range (μg/mL) | Incubation Time | IC50 (μg/mL) | Ref. |
|---|---|---|---|---|---|---|---|
| CuO * | ~55 | Spherical | HEK 293 | 0–1000 | 24 h | 410 | [98] |
| CuO * | ~40 | Spherical | A 549 | 0–80 | 18 h | <40 | [108] |
| ~3000 | Spherical | A 549 | 0–80 | 18 h | >80 | [109] | |
| CuO | ~55 | Spherical | HEK 293 | 0–300 | 48 h | 65.5 | [96] |
| CuO | <50 | Spherical | HEK 293 | 0–25 | 24 h | 2.5 | [97] |
| <50 | Spherical | MRC 5 | 0–25 | 24 h | ~1.25 | [97] | |
| <50 | Spherical | HeLa | 0–25 | 24 h | ~1.25 | [97] | |
| <50 | Spherical | HCT 116 | 0–25 | 24 h | 5 | [97] | |
| CuO | ~12 | Spherical | A 549 | 0–100 | 24 h | ~19 | [93] |
| ~12 | Spherical | Caco2 | 0–100 | 24 h | ~13 | [93] | |
| ~12 | Spherical | Balb/c 3T3 | 0–100 | 24 h | ~18 | [93] | |
| CuO | 50–70 | Rods | HepG2 | 0–100 | 24 h | 85 | [110] |
| 50–70 | Rods | SK-Hep 1 | 0–100 | 24 h | 25 | [110] | |
| ZnO | ~90 | Spherical | HEK 293 | 0–100 | 24 h | ~25 | [99] |
| ~90 | Spherical | HEK 293 | 0–100 | 48 h | >50 | [99] | |
| ZnO | ~110 | Rods–spherical | HK 2 | 0–100 | 24 h | ~20 | [111] |
| ZnO * | 20–1000 | Irregular spherical | HEK 293 | 0–100 | 24 h | >100 | [100] |
| 20–1000 | Irregular spherical | MFC 7 | 0–100 | 24 h | ~60 | [100] | |
| ZnO | >100 | Spherical | HEK 293 | 0–50 | 24 h | ~21 | [101] |
| >100 | Spherical | HEK 293 | 0–50 | 48 h | ~20 | [101] | |
| >100 | Spherical | HEK 293 | 0–50 | 72 h | ~17 | [101] | |
| ZnO | ~20 | Rods–spherical | HEK 293 | 0–1000 | 24 h | ~53 | [102] |
| ~20 | Rods–spherical | T98G | 0–1000 | 24 h | ~17 | [102] | |
| ~20 | Rods–spherical | KB | 0–1000 | 24 h | ~38 | [102] | |
| ZnO | 25–40 | Spherical | HEK 293 | 0–100 | 3 h | >100 | [103] |
| 25–40 | Spherical | HEK 293 | 0–100 | 24 h | >75 | [103] | |
| 25–40 | Spherical | HEK 293 | 0–100 | 48 h | >50 | [103] | |
| ZnO | ~20 | Spherical | A 549 | 0–100 | 24 h | ~25 | [93] |
| ~20 | Spherical | Caco2 | 0–100 | 24 h | ~30. | [93] | |
| ~20 | Spherical | Balb/c 3T3 | 0–100 | 24 h | ~12 | [93] | |
| Co | ~28 | n.d. | HDMEC | 0–50 | 24 h | >50 | [112] |
| CoO | ~62 | Spherical | lymphocyte | 0–50 | 24 h | ~25 | [113] |
| Co | ~25 | Spherical–polygonal | A 459 | 0–100 | 24 h | ~93 | [94] |
| CoO | ~43 | Spherical | A 459 | 0–100 | 24 h | inactive | [94] |
| Co3O4 | ~51 | Clusters | A 459 | 0–100 | 24 h | inactive | [94] |
| Co3O4 | ~22 | Hexagonal | A 549 | 0–40 | 24 h | inactive | [104] |
| ~22 | Hexagonal | BEAS-2B | 0–40 | 24 h | >40 | [104] | |
| Co3O4 | ~47 | Polygonal | HepG2 | 0–100 | 24 h | inactive | [114] |
| ~47 | Polygonal | Caco 2 | 0–100 | 24 h | inactive | [113] | |
| ~47 | Polygonal | HepG2 | 0–100 | 24 h | inactive | [113] | |
| ~47 | Polygonal | A 549 | 0–1000 | 24 h | ~409 | [113] | |
| Co3O4 | ~9 | Polygonal | A 549 | 0–100 | 24 h | ~131 | [93] |
| ~9 | Polygonal | Caco2 | 0–100 | 24 h | ~123 | [93] | |
| ~9 | Polygonal | Balb/c 3T3 | 0–100 | 24 h | ~135 | [93] | |
| Cu0.88Zn0.12O | 2–10 | Aggregate | HepG2 | 0–50 | 48 h | ~10 | [105] |
| 2–10 | Aggregate | Bel7402 | 0–60 | 48 h | ~35.6 | [105] | |
| 2–10 | Aggregate | A 549 | ~24.4 | [105] | |||
| 2–10 | Aggregate | Panc28 | 0–10 | 48 h | ~9.2 | [105] | |
| 2–10 | Aggregate | HT1080 | 0–20 | 48 h | ~25.8 | [105] | |
| 2–10 | Aggregate | HELA | 0–20 | 48 h | ~6.5 | [105] | |
| 2–10 | Aggregate | HUVEC | 0–200 | 48 h | ~148.6 | [105] | |
| 2–10 | Aggregate | LO2 | 0–250 | 48 h | ~294.94 | [105] | |
| Cu100 | ~20 | Spherical | HEK 293 | 0–400 | 24 h | ~87 ** | This work |
| Cu90Zn10 | ~20 | Spherical | HEK 293 | 0–400 | 24 h | ~76 ** | This work |
| Cu87Zn10Co3 | ~50 | Hyrdangea | HEK 293 | 0–400 | 24 h | ~68 ** | This work |
Disclaimer/Publisher’s Note: The statements, opinions and data contained in all publications are solely those of the individual author(s) and contributor(s) and not of MDPI and/or the editor(s). MDPI and/or the editor(s) disclaim responsibility for any injury to people or property resulting from any ideas, methods, instructions or products referred to in the content. |
© 2023 by the authors. Licensee MDPI, Basel, Switzerland. This article is an open access article distributed under the terms and conditions of the Creative Commons Attribution (CC BY) license (https://creativecommons.org/licenses/by/4.0/).
Share and Cite
Bauer, E.M.; Talone, A.; Imperatori, P.; Briancesco, R.; Bonadonna, L.; Carbone, M. The Addition of Co into CuO–ZnO Oxides Triggers High Antibacterial Activity and Low Cytotoxicity. Nanomaterials 2023, 13, 2823. https://doi.org/10.3390/nano13212823
Bauer EM, Talone A, Imperatori P, Briancesco R, Bonadonna L, Carbone M. The Addition of Co into CuO–ZnO Oxides Triggers High Antibacterial Activity and Low Cytotoxicity. Nanomaterials. 2023; 13(21):2823. https://doi.org/10.3390/nano13212823
Chicago/Turabian StyleBauer, Elvira Maria, Alessandro Talone, Patrizia Imperatori, Rossella Briancesco, Lucia Bonadonna, and Marilena Carbone. 2023. "The Addition of Co into CuO–ZnO Oxides Triggers High Antibacterial Activity and Low Cytotoxicity" Nanomaterials 13, no. 21: 2823. https://doi.org/10.3390/nano13212823
APA StyleBauer, E. M., Talone, A., Imperatori, P., Briancesco, R., Bonadonna, L., & Carbone, M. (2023). The Addition of Co into CuO–ZnO Oxides Triggers High Antibacterial Activity and Low Cytotoxicity. Nanomaterials, 13(21), 2823. https://doi.org/10.3390/nano13212823








